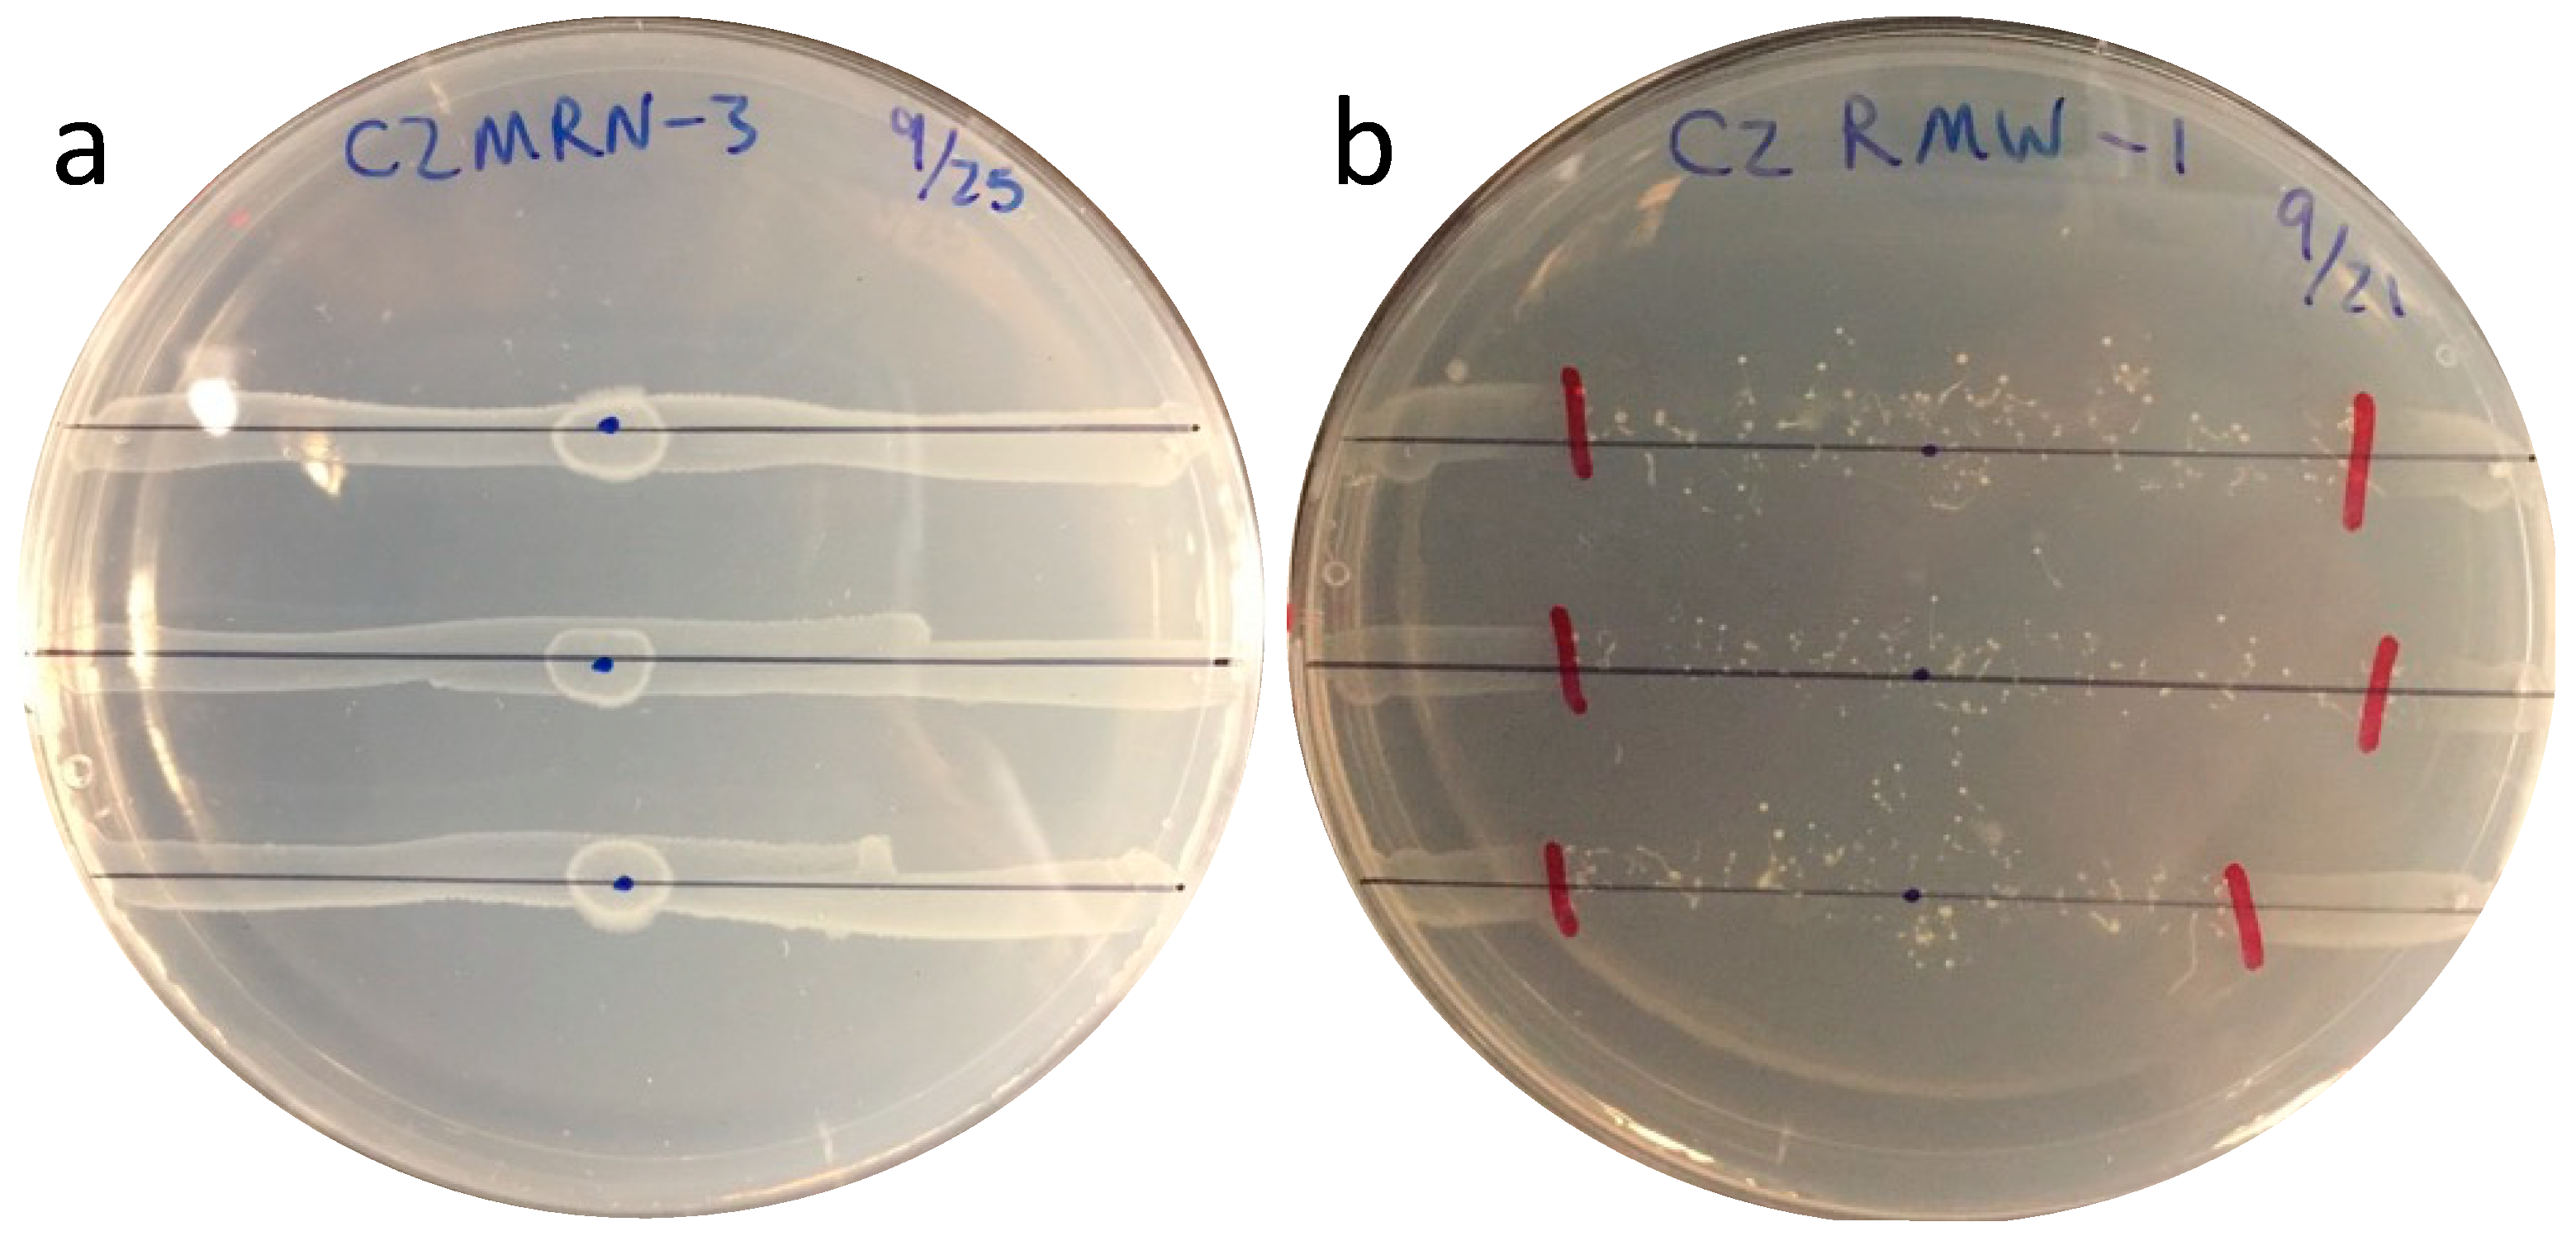

Escherichia coli Strains Display Varying Susceptibility to Grazing by the Soil Amoeba Dictyostelium discoideum
Abstract
1. Introduction
2. Materials and Methods
2.1. Strains Evaluated
2.2. Culturing Conditions
2.3. Grazing Assay
2.4. Grazing Preferences by Amoeba
2.5. Genome Analysis of Most and Least Grazed Isolates
2.6. Genes Associated with Grazing Susceptibility of E. coli Isolates
3. Results
3.1. Grazing Susceptibility
3.2. Grazing Preferences by D. discoideum
3.3. Presence of Virulence Genes and Grazing Susceptibility
3.4. Genomes of Grazing-Susceptible versus -Resistant Isolates
4. Discussion
5. Conclusions
Supplementary Materials
Author Contributions
Funding
Data Availability Statement
Conflicts of Interest
References
- Foster-Nyarko, E.; Pallen, M.J. The Microbial Ecology of Escherichia coli in the Vertebrate Gut. FEMS Microbiol. Rev. 2022, 46, fuac008. [Google Scholar] [CrossRef]
- Pokharel, P.; Dhakal, S.; Dozois, C.M. The Diversity of Escherichia coli Pathotypes and Vaccination Strategies against This Versatile Bacterial Pathogen. Microorganisms 2023, 11, 344. [Google Scholar] [CrossRef] [PubMed]
- Pachepsky, Y.A.; Shelton, D.R. Escherichia coli and Fecal coliforms in Freshwater and Estuarine Sediments. Crit. Rev. Environ. Sci. Technol. 2011, 41, 1067–1110. [Google Scholar] [CrossRef]
- Ishii, S.; Ksoll, W.B.; Hicks, R.E.; Sadowsky, M.J. Presence and Growth of Naturalized Escherichia coli in Temperate Soils from Lake Superior Watersheds. Appl. Environ. Microbiol. 2006, 72, 612–621. [Google Scholar] [CrossRef]
- Jang, J.; Hur, H.-G.; Sadowsky, M.J.; Byappanahalli, M.N.; Yan, T.; Ishii, S. Environmental Escherichia coli: Ecology and Public Health Implications—A Review. J. Appl. Microbiol. 2017, 123, 570–581. [Google Scholar] [CrossRef]
- van Elsas, J.D.; Semenov, A.V.; Costa, R.; Trevors, J.T. Survival of Escherichia coli in the Environment: Fundamental and Public Health Aspects. ISME J. 2011, 5, 173–183. [Google Scholar] [CrossRef]
- Power, M.L.; Littlefield-Wyer, J.; Gordon, D.M.; Veal, D.A.; Slade, M.B. Phenotypic and Genotypic Characterization of Encapsulated Escherichia coli Isolated from Blooms in Two Australian Lakes. Environ. Microbiol. 2005, 7, 631–640. [Google Scholar] [CrossRef] [PubMed]
- Texier, S.; Prigent-Combaret, C.; Gourdon, M.H.; Poirier, M.A.; Faivre, P.; Dorioz, J.M.; Poulenard, J.; Jocteur-Monrozier, L.; Moënne-Loccoz, Y.; Trevisan, D. Persistence of Culturable Escherichia coli Fecal Contaminants in Dairy Alpine Grassland Soils. J. Environ. Qual. 2008, 37, 2299–2310. [Google Scholar] [CrossRef] [PubMed]
- NandaKafle, G.; Seale, T.; Flint, T.; Nepal, M.; Venter, S.N.; Brözel, V.S. Distribution of Diverse Escherichia coli between Cattle and Pasture. Microbes Environ. 2017, 32, 226–233. [Google Scholar] [CrossRef] [PubMed]
- Dusek, N.; Hewitt, A.J.; Schmidt, K.N.; Bergholz, P.W. Landscape-Scale Factors Affecting the Prevalence of Escherichia coli in Surface Soil Include Land Cover Type, Edge Interactions, and Soil PH. Appl. Environ. Microbiol. 2018, 84, e02714-17. [Google Scholar] [CrossRef]
- NandaKafle, G.; Christie, A.A.; Vilain, S.; Brözel, V.S. Growth and Extended Survival of Escherichia coli O157: H7 in Soil Organic Matter. Front. Microbiol. 2018, 9, 762. [Google Scholar] [CrossRef] [PubMed]
- Liebeke, M.; Brözel, V.S.; Hecker, M.; Lalk, M. Chemical Characterization of Soil Extract as Growth Media for the Ecophysiological Study of Bacteria. Appl. Microbiol. Biotechnol. 2009, 83, 161–173. [Google Scholar] [CrossRef] [PubMed]
- Finkel, S.E. Long-Term Survival during Stationary Phase: Evolution and the GASP Phenotype. Nat. Rev. Microbiol. 2006, 4, 113–120. [Google Scholar] [CrossRef]
- Jiang, X.; Morgan, J.; Doyle, M.P. Fate of Escherichia coli O157:H7 in Manure-Amended Soil. Appl. Environ. Microbiol. 2002, 68, 2605–2609. [Google Scholar] [CrossRef]
- Semenov, A.V.; van Bruggen, A.H.C.; van Overbeek, L.; Termorshuizen, A.J.; Semenov, A.M. Influence of Temperature Fluctuations on Escherichia coli O157:H7 and Salmonella Enterica Serovar Typhimurium in Cow Manure. FEMS Microbiol. Ecol. 2007, 60, 419–428. [Google Scholar] [CrossRef]
- Feng, F.; Goto, D.; Yan, T. Effects of Autochthonous Microbial Community on the Die-off of Fecal Indicators in Tropical Beach Sand. FEMS Microbiol. Ecol. 2010, 74, 214–225. [Google Scholar] [CrossRef]
- Wanjugi, P.; Fox, G.A.; Harwood, V.J. The Interplay Between Predation, Competition, and Nutrient Levels Influences the Survival of Escherichia coli in Aquatic Environments. Microb. Ecol. 2016, 72, 526–537. [Google Scholar] [CrossRef]
- Korajkic, A.; Wanjugi, P.; Harwood, V.J. Indigenous Microbiota and Habitat Influence Escherichia coli Survival More than Sunlight in Simulated Aquatic Environments. Appl. Environ. Microbiol. 2013, 79, 5329–5337. [Google Scholar] [CrossRef] [PubMed]
- Bar-On, Y.M.; Phillips, R.; Milo, R. The Biomass Distribution on Earth. Proc. Natl. Acad. Sci. USA 2018, 115, 6506–6511. [Google Scholar] [CrossRef] [PubMed]
- Kurm, V.; van der Putten, W.H.; Weidner, S.; Geisen, S.; Snoek, B.L.; Bakx, T.; Hol, W.H.G. Competition and Predation as Possible Causes of Bacterial Rarity. Environ. Microbiol. 2019, 21, 1356–1368. [Google Scholar] [CrossRef]
- Pernthaler, J. Predation on Prokaryotes in the Water Column and Its Ecological Implications. Nat. Rev. Microbiol. 2005, 3, 537–546. [Google Scholar] [CrossRef] [PubMed]
- Shi, Y.; Queller, D.C.; Tian, Y.; Zhang, S.; Yan, Q.; He, Z.; He, Z.; Wu, C.; Wang, C.; Shu, L. The Ecology and Evolution of Amoeba-Bacterium Interactions. Appl. Environ. Microbiol. 2021, 87, e01866-20. [Google Scholar] [CrossRef]
- Matz, C.; Kjelleberg, S. Off the Hook—How Bacteria Survive Protozoan Grazing. Trends Microbiol. 2005, 13, 302–307. [Google Scholar] [CrossRef] [PubMed]
- Sato, K.; Taniyama, Y.; Yoshida, A.; Toyomasu, K.; Ryuda, N.; Ueno, D.; Someya, T. Protozoan Predation of Escherichia coli in Hydroponic Media of Leafy Vegetables. Soil Sci. Plant Nutr. 2019, 65, 234–242. [Google Scholar] [CrossRef]
- Kihara, K.; Mori, K.; Suzuki, S.; Hosoda, K.; Yamada, A.; Matsuyama, S.; Kashiwagi, A.; Yomo, T. Probabilistic Transition from Unstable Predator–Prey Interaction to Stable Coexistence of Dictyostelium Discoideum and Escherichia coli. Biosystems 2011, 103, 342–347. [Google Scholar] [CrossRef]
- Weekers, P.H.H.; Bodelier, P.L.E.; Wijen, J.P.H.; Vogels, G.D. Effects of Grazing by the Free-Living Soil Amoebae Acanthamoeba Castellanii, Acanthamoeba Polyphaga, and Hartmannella Vermiformis on Various Bacteria. Appl. Environ. Microbiol. 1993, 59, 2317–2319. [Google Scholar] [CrossRef]
- Ravva, S.V.; Sarreal, C.Z.; Mandrell, R.E. Identification of Protozoa in Dairy Lagoon Wastewater That Consume Escherichia coli O157:H7 Preferentially. PLoS ONE 2010, 5, e15671. [Google Scholar] [CrossRef]
- Adiba, S.; Nizak, C.; van Baalen, M.; Denamur, E.; Depaulis, F. From Grazing Resistance to Pathogenesis: The Coincidental Evolution of Virulence Factors. PLoS ONE 2010, 5, e11882. [Google Scholar] [CrossRef]
- González, J.M.; Iriberri, J.; Egea, L.; Barcina, I. Differential Rates of Digestion of Bacteria by Freshwater and Marine Phagotrophic Protozoa. Appl. Environ. Microbiol. 1990, 56, 1851–1857. [Google Scholar] [CrossRef]
- Iriberri, J.; Azúa, I.; Labirua-Iturburu, A.; Artolozaga, I.; Barcina, I. Differential Elimination of Enteric Bacteria by Protists in a Freshwater System. J. Appl. Bacteriol. 1994, 77, 476–483. [Google Scholar] [CrossRef]
- Meltz Steinberg, K.; Levin, B.R. Grazing Protozoa and the Evolution of the Escherichia coli O157:H7 Shiga Toxin-Encoding Prophage. Proc. R. Soc. B Biol. Sci. 2007, 274, 1921–1929. [Google Scholar] [CrossRef] [PubMed]
- Ravva, S.V.; Sarreal, C.Z.; Mandrell, R.E. Strain Differences in Fitness of Escherichia coli O157:H7 to Resist Protozoan Predation and Survival in Soil. PLoS ONE 2014, 9, e102412. [Google Scholar] [CrossRef] [PubMed]
- Tezcan-Merdol, D.; Ljungström, M.; Winiecka-Krusnell, J.; Linder, E.; Engstrand, L.; Rhen, M. Uptake and Replication of Salmonella Enterica in Acanthamoeba Rhysodes. Appl. Environ. Microbiol. 2004, 70, 3706–3714. [Google Scholar] [CrossRef]
- Wildschutte, H.; Wolfe, D.M.; Tamewitz, A.; Lawrence, J.G. Protozoan Predation, Diversifying Selection, and the Evolution of Antigenic Diversity in Salmonella. Proc. Natl. Acad. Sci. USA 2004, 101, 10644–10649. [Google Scholar] [CrossRef]
- Smith, D.D.N.; Nickzad, A.; Déziel, E.; Stavrinides, J. A Novel Glycolipid Biosurfactant Confers Grazing Resistance upon Pantoea Ananatis BRT175 against the Social Amoeba Dictyostelium Discoideum. mSphere 2016, 1, e00075-15. [Google Scholar] [CrossRef]
- Jenkins, M.B.; Fisher, D.S.; Endale, D.M.; Adams, P. Comparative Die-off of Escherichia coli 0157:H7 and Fecal Indicator Bacteria in Pond Water. Environ. Sci. Technol. 2011, 45, 1853–1858. [Google Scholar] [CrossRef]
- Artz, R.R.E.; Killham, K. Survival of Escherichia coli O157:H7 in Private Drinking Water Wells: Influences of Protozoan Grazing and Elevated Copper Concentrations. FEMS Microbiol. Lett. 2002, 216, 117–122. [Google Scholar] [CrossRef]
- Avery, L.M.; Williams, A.P.; Killham, K.; Jones, D.L. Survival of Escherichia coli O157:H7 in Waters from Lakes, Rivers, Puddles and Animal-Drinking Troughs. Sci. Total Environ. 2008, 389, 378–385. [Google Scholar] [CrossRef]
- Schmidt, C.E.; Shringi, S.; Besser, T.E. Protozoan Predation of Escherichia coli O157:H7 Is Unaffected by the Carriage of Shiga Toxin-Encoding Bacteriophages. PLoS ONE 2016, 11, e0147270. [Google Scholar] [CrossRef]
- Hahn, M.W.; Höfle, M.G. Grazing of Protozoa and Its Effect on Populations of Aquatic Bacteria. FEMS Microbiol. Ecol. 2001, 35, 113–121. [Google Scholar] [CrossRef]
- Jürgens, K.; Matz, C. Predation as a Shaping Force for the Phenotypic and Genotypic Composition of Planktonic Bacteria. Antonie Van Leeuwenhoek 2002, 81, 413–434. [Google Scholar] [CrossRef]
- Moore, D.M.; Withers, T.R.; Yu, H.; Trzyna, W. A Simple Plating Assay Using Acanthamoeba to Evaluate the Effect of Environmental Stressors on Growing and Dividing Cells. Proc. West Va. Acad. Sci. 2016, 88. [Google Scholar] [CrossRef]
- R: The R Project for Statistical Computing. Available online: https://www.r-project.org/ (accessed on 26 April 2023).
- Bolger, A.M.; Lohse, M.; Usadel, B. Trimmomatic: A Flexible Trimmer for Illumina Sequence Data. Bioinformatics 2014, 30, 2114–2120. [Google Scholar] [CrossRef]
- Bankevich, A.; Nurk, S.; Antipov, D.; Gurevich, A.A.; Dvorkin, M.; Kulikov, A.S.; Lesin, V.M.; Nikolenko, S.I.; Pham, S.; Prjibelski, A.D.; et al. SPAdes: A New Genome Assembly Algorithm and Its Applications to Single-Cell Sequencing. J. Comput. Biol. 2012, 19, 455–477. [Google Scholar] [CrossRef]
- Seemann, T. Prokka: Rapid Prokaryotic Genome Annotation. Bioinformatics 2014, 30, 2068–2069. [Google Scholar] [CrossRef]
- Dieckmann, M.A.; Beyvers, S.; Nkouamedjo-Fankep, R.C.; Hanel, P.H.G.; Jelonek, L.; Blom, J.; Goesmann, A. EDGAR3.0: Comparative Genomics and Phylogenomics on a Scalable Infrastructure. Nucleic Acids Res. 2021, 49, W185–W192. [Google Scholar] [CrossRef]
- Edgar, R.C. MUSCLE: Multiple Sequence Alignment with High Accuracy and High Throughput. Nucleic Acids Res. 2004, 32, 1792–1797. [Google Scholar] [CrossRef]
- Darriba, D.; Taboada, G.L.; Doallo, R.; Posada, D. ProtTest-HPC: Fast Selection of Best-Fit Models of Protein Evolution. In Proceedings of the Euro-Par 2010 Parallel Processing Workshops, Iscia, Italy, 31 August–3 September 2010; Guarracino, M.R., Vivien, F., Träff, J.L., Cannatoro, M., Danelutto, M., Hast, A., Perla, F., Knüpfer, A., Di Martino, B., Alexander, M., Eds.; Springer: Berlin/Heidelberg, Germany, 2011; pp. 177–184. [Google Scholar]
- Kück, P.; Longo, G.C. FASconCAT-G: Extensive Functions for Multiple Sequence Alignment Preparations Concerning Phylogenetic Studies. Front. Zool. 2014, 11, 81. [Google Scholar] [CrossRef]
- Stamatakis, A. RAxML-VI-HPC: Maximum Likelihood-Based Phylogenetic Analyses with Thousands of Taxa and Mixed Models. Bioinformatics 2006, 22, 2688–2690. [Google Scholar] [CrossRef]
- Hammer, O.; Harper, D.A.T.; Ryan, P.D. PAST: Paleontological Statistics Software Package for Education and Data Analysis. Palaeontol. Electron. 2001, 4, 178kb. [Google Scholar]
- Blom, J.; Kreis, J.; Spänig, S.; Juhre, T.; Bertelli, C.; Ernst, C.; Goesmann, A. EDGAR 2.0: An Enhanced Software Platform for Comparative Gene Content Analyses. Nucleic Acids Res. 2016, 44, W22–W28. [Google Scholar] [CrossRef]
- Barker, J.; Humphrey, T.J.; Brown, M.W.R. Survival of Escherichia coli 0157 in a Soil Protozoan: Implications for Disease. FEMS Microbiol. Lett. 1999, 173, 291–295. [Google Scholar] [CrossRef]
- Snyder, M.; Weichseldorfer, M.; Lane, J.; Kazmierski, R.; Bains, H.; White, T.; Parker, D.; Aklkharouf, N.; Hemm, M. Identification of Virulence and Virulence Regulatory Factors in Escherichia coli Using Dictyostelium Discoideum as a Model Phagocyte. J. Immunol. 2017, 198 (Suppl. S1), 131.19. [Google Scholar] [CrossRef]
- Sillo, A.; Matthias, J.; Konertz, R.; Bozzaro, S.; Eichinger, L. Salmonella Typhimurium Is Pathogenic for Dictyostelium Cells and Subverts the Starvation Response. Cell. Microbiol. 2011, 13, 1793–1811. [Google Scholar] [CrossRef]
- Cianciotto, N.P.; White, R.C. Expanding Role of Type II Secretion in Bacterial Pathogenesis and Beyond. Infect. Immun. 2017, 85, e00014-17. [Google Scholar] [CrossRef]
- Federle, M.J. Autoinducer-2-Based Chemical Communication in Bacteria: Complexities of Interspecies Signaling. In Bacterial Sensing and Signaling; Karger Publishers: Basel, Switzerland, 2009; Volume 16, pp. 18–32. [Google Scholar]
- Van der Henst, C.; Scrignari, T.; Maclachlan, C.; Blokesch, M. An Intracellular Replication Niche for Vibrio Cholerae in the Amoeba Acanthamoeba Castellanii. ISME J. 2016, 10, 897–910. [Google Scholar] [CrossRef]
- Brock, D.A.; Douglas, T.E.; Queller, D.C.; Strassmann, J.E. Primitive Agriculture in a Social Amoeba. Nature 2011, 469, 393–396. [Google Scholar] [CrossRef]

| Highly Grazed Group—HGG (Susceptible) | Least Grazed Group—LGG (Resistant) |
|---|---|
| Membrane protein: 33 | Membrane protein: 8 |
| D-methionine-binding lipoprotein MetQ precursor, 00706 | LPS assembly protein LptD, 02333 |
| Outer membrane protein IcsA autotransporter precursor, 01754 | Periplasmic trehalase, 04132 |
| Outer membrane usher protein FimD precursor, 00603 | Inner membrane protein YijD, 04745 |
| Putative outer membrane usher protein ElfC precursor, 02959 | Cryptic outer membrane porin BglH, 02531 |
| Threonine-rich inner membrane protein GfcA precursor, 03321 | Inner membrane protein YmfA, 02786 |
| Putative lipoprotein GfcB precursor, 03320 | Inner membrane protein YcfZ, 02787 |
| Bestrophin, RFP-TM, chloride channel, 04701 | Outer membrane usher protein PapC, 03086 |
| Outer membrane usher protein FimD precursor, 04713 | Major curlin subunit, 02865 |
| Outer membrane porin protein OmpD precursor, 05195 | |
| Inner membrane protein YnbA, 05048 | |
| Outer membrane protein G precursor, 03566 | |
| Inner membrane ABC transporter permease protein YcjP, 03559 | |
| Inner membrane ABC transporter permease protein YcjO, 03558 | |
| Inner membrane protein YnjI, 00078 | |
| Inner membrane metabolite transport protein YdjE, 00071 | |
| Inner membrane metabolite transport protein YdjE, 00065 | |
| Inner membrane protein YedR, 04633 | |
| Putative inner membrane protein, 04857 | |
| Lipoprotein YlpA precursor, 05409 | |
| Type IV conjugative transfer system lipoprotein (TraV), 05429 | |
| Outer membrane protein IcsA autotransporter precursor, 03405 | |
| Inner membrane protein YmgF, 03404 | |
| InvH outer membrane lipoprotein, 02742 | |
| Lipoprotein PrgK precursor, 02737 | |
| Phospholipase YtpA, 05051 | |
| Putative penicillin-binding protein PbpX, 00929 | |
| Inner membrane protein YiaV precursor, 01085 | |
| Inner membrane protein YiaW, 01084 | |
| Inner membrane protein YidI, 03190 | |
| Putative outer membrane usher protein ElfC precursor, 01369 | |
| Inner membrane protein YihN, 01208 | |
| Energy-coupling factor transporter transmembrane protein EcfT, 02823 | |
| Inner membrane protein YhaI, 02855 | |
| Transporter protein: 23 | Transporter protein: 10 |
| Putative transporter YycB, 03297 | Ribose import permease protein RbsC, 00866 |
| 4-hydroxybenzoate transporter PcaK, 01955 | Ribose import ATP-binding protein RbsA, 00865 |
| Inner membrane transporter YcaM, 02919 | Putrescine transporter PotE, 03286 |
| Polysialic acid transport protein KpsD precursor, 03317 | Autoinducer 2 import system permease protein LsrD, 00867 |
| Putative autotransporter precursor, 03444 | Electron transport complex subunit RsxC, 01281 |
| Proline/betaine transporter, 04676 | Fe2+ transporter FeoB, 02631 |
| Sugar efflux transporter, 04692 | L-fucose-proton symporter, 01383 |
| Multidrug transporter EmrE, 00208 | C4-dicarboxylate TRAP transporter permease protein DctM, 01554 |
| Putative D,D-dipeptide transport system permease protein DdpB, 05180 | D-galactonate transporter, 02501 |
| Putative D,D-dipeptide transport ATP-binding protein DdpD, 05182 | Sialic acid TRAP transporter small permease protein SiaQ, 01553 |
| Putative D,D-dipeptide transport ATP-binding protein DdpF, 05183 | |
| L-carnitine/gamma-butyrobetaine antiporter, 00040 | |
| Putative autotransporter precursor, 04851 | |
| Putative autotransporter precursor, 03444 | |
| Yop proteins translocation protein F, 02739 | |
| Sugar efflux transporter C, 00997 | |
| Putrescine importer PuuP, 03543 | |
| L-carnitine/gamma-butyrobetaine antiporter, 00040 | |
| Putative formate transporter 1, 00871 | |
| Inner membrane ABC transporter permease protein YtfT, 03372 | |
| Energy-coupling factor transporter ATP-binding protein EcfA1, 02824 | |
| Energy-coupling factor transporter ATP-binding protein EcfA1, 02825 | |
| High-affinity glucose transporter, 02206 | |
| Virulence related: 24 | Virulence related: 4 |
| Type-1 fimbrial protein, A chain precursor, 00605 | Putative fimbrial-like protein YadM, 04227 |
| Chaperone protein FimC precursor, 00604 | Invasin, 00840 |
| Putative fimbrial-like protein ElfG precursor, 00602 | Putative fimbrial-like protein YbgD, 03085 |
| Type-1 fimbrial protein, A chain precursor, 00601 | Putative fimbrial-like protein YadM, 04227 |
| Fimbrial A protein precursor, 01601 | |
| Virulence factors putative positive transcription regulator BvgA, 00600 | |
| Putative fimbrial chaperone protein ElfD precursor, 02958 | |
| Fimbrial subunit ElfA precursor, 02957 | |
| Putative fimbrial-like protein ElfG precursor, 02960 | |
| Putative fimbrial-like protein YcbU precursor, 02961 | |
| Putative fimbrial-like protein YcbV precursor, 02962 | |
| Putative fimbrial chaperone YcbF precursor, 02963 | |
| Hemolysin E, chromosomal, 03417 | |
| IDENTICAL PARALOGS Small toxic polypeptide LdrD Small toxic polypeptide LdrD, 04573 & 04574 | |
| S-fimbrial protein subunit SfaG precursor, 04714 | |
| S-fimbrial adhesin protein SfaS precursor, 04715 | |
| S-fimbrial protein subunit SfaH, 04716 | |
| Flagellin, 02361 | |
| Small toxic protein TisB, 03185 | |
| Flagellar biosynthesis protein FliR, 02744 | |
| Flagellar biosynthesis protein FliQ, 02745 | |
| Flagellar biosynthetic protein FliP precursor, 02746 | |
| Putative fimbrial-like protein ElfG precursor, 01370 | |
| Type-1 fimbrial protein, A chain precursor, 01367 | |
| Toxin antitoxin system: 12 | Toxin antitoxin system: 4 |
| Antitoxin DinJ, 00418 | Toxin YoeB, 02097 |
| Antitoxin ParD1, 03953 | Antitoxin YefM, 02096 |
| Antitoxin HicB, 01856 | Toxin HigB-2, 04560 |
| Antitoxin ParD1, 03953 | Antitoxin HigA-2, 04561 |
| Antitoxin VapB, 01875 | |
| Antitoxin HipB, 04711 | |
| Toxin ParE1, 03952 | |
| Antitoxin MazE, 02588 | |
| Antitoxin PrlF, 04802 | |
| Toxin YhaV, 04801 | |
| Antitoxin HigA, 02876 | |
| Antitoxin ChpS, 03367 | |
| Quorum sensing: 7 | Quorum sensing: 1 |
| Autoinducer 2-binding protein LsrB precursor, 04705 | Autoinducer 2-binding protein LsrB, 00864 |
| Autoinducer 2 import system permease protein LsrD, 04706 | |
| Autoinducer 2 import system permease protein LsrC, 04707 | |
| Autoinducer 2 import ATP-binding protein LsrA, 04708 | |
| Transcriptional regulator LsrR, 04709 | |
| Autoinducer 2 kise LsrK, 04710 | |
| Autoinducer 2-degrading protein LsrG, 04703, | |
| Stress protein: 2 | Stress protein: 2 |
| Stress-induced bacterial acidophilic repeat motif protein, 00310 | General stress protein A, 02418 |
| General stress protein 69, 00069 | General stress protein A, 02415 |
| Secretory protein: 4 | Secretory protein: 13 |
| Secreted effector protein pipB2, 04251 | Putative type II secretion system protein D, 04794 |
| Type III secretion system protein SpaO, 02748 | Type II secretion system protein E, 03006 |
| Type III secretion system protein PrgH-EprH (PrgH), 02740 | Type II secretion system protein F, 03005 |
| Type III secretion system protein SpaO, 02748 | Putative type II secretion system protein G, 04791 |
| Type II secretion system protein M, 02998 | |
| Type II secretion system protein L, 02999 | |
| Putative type II secretion system protein K, 03000 | |
| Type II secretion system protein J, 03001 | |
| Type II secretion system protein I, 03002 | |
| Type II secretion system protein H, 03003 | |
| Type II secretion system protein G, 03004 | |
| Type II secretion system protein D, 03007 | |
| Type II secretion system protein C, 03008 |
Disclaimer/Publisher’s Note: The statements, opinions and data contained in all publications are solely those of the individual author(s) and contributor(s) and not of MDPI and/or the editor(s). MDPI and/or the editor(s) disclaim responsibility for any injury to people or property resulting from any ideas, methods, instructions or products referred to in the content. |
© 2023 by the authors. Licensee MDPI, Basel, Switzerland. This article is an open access article distributed under the terms and conditions of the Creative Commons Attribution (CC BY) license (https://creativecommons.org/licenses/by/4.0/).
Share and Cite
NandaKafle, G.; Blasius, L.A.; Seale, T.; Brözel, V.S. Escherichia coli Strains Display Varying Susceptibility to Grazing by the Soil Amoeba Dictyostelium discoideum. Microorganisms 2023, 11, 1457. https://doi.org/10.3390/microorganisms11061457
NandaKafle G, Blasius LA, Seale T, Brözel VS. Escherichia coli Strains Display Varying Susceptibility to Grazing by the Soil Amoeba Dictyostelium discoideum. Microorganisms. 2023; 11(6):1457. https://doi.org/10.3390/microorganisms11061457
Chicago/Turabian StyleNandaKafle, Gitanjali, Lane A. Blasius, Tarren Seale, and Volker S. Brözel. 2023. "Escherichia coli Strains Display Varying Susceptibility to Grazing by the Soil Amoeba Dictyostelium discoideum" Microorganisms 11, no. 6: 1457. https://doi.org/10.3390/microorganisms11061457
APA StyleNandaKafle, G., Blasius, L. A., Seale, T., & Brözel, V. S. (2023). Escherichia coli Strains Display Varying Susceptibility to Grazing by the Soil Amoeba Dictyostelium discoideum. Microorganisms, 11(6), 1457. https://doi.org/10.3390/microorganisms11061457

